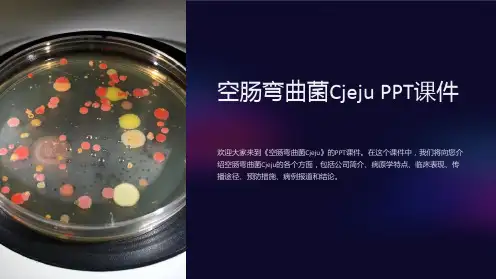

空肠弯曲菌讲解
- 格式:ppt
- 大小:237.00 KB
- 文档页数:1





空肠弯曲菌一、空肠弯曲菌是什么空肠弯曲菌是一种人畜共患病的病原菌,可以引起人和动物发生多种疾病,并且是一种可以通过不洁食物传播给人的致病菌。
在大多数温血动物中广泛存在,在诸如家禽、牛、猪、羊、鸵鸟等食用动物肠道中,以及在包括猫和狗等宠物的肠道中十分普遍。
二、危害是什么空肠弯曲菌是一种食物源性病原菌,被认为是引起全世界人类细菌性腹泻的主要原因。
人感染空肠弯曲菌后可引起发热、急性肠炎和格林—巴利综合征。
三、在我国的流行状况据美国疾病预防控制中心报道,空肠弯曲菌在美国以散发病例为主,每10万名腹泻病例中确证感染14例,考虑到漏诊的情况,预计美国每年有130万人收到空肠弯曲菌感染影响。
该菌导致的暴发在美国少见,最近一次暴发发生在2013年5月的宾夕法尼亚州,因牛奶消毒不彻底导致148例发病。
我国的情况与美国相似,也是病例以散发为主,暴发少见报道。
该菌引起的肠炎在夏天高发,婴儿和青年人感染率高于其它年龄段人群,男性高于女性。
四、最常见的污染食品是什么污染食品主要是禽畜肉、生鲜奶。
病人通过进食未煮熟的肉类及肉制品产品、奶制品等感染,此外,受污染的水或者冰也是一个感染来源。
五、最常见发生的地点常见于各类集体食堂、宾馆饭店甚至是家庭,如果厨房加工卫生条件不良,均可能引起该菌的感染而发病。
六、典型症状是什么人们通常在感染该菌之后的2-5天后出现疾病症状,也可能1天到10天不等,但多数空肠弯曲菌感染者无临床症状。
其最常见临床症状包括发热、头痛、腹痛、腹泻(经常伴有便血)、恶心和/或呕吐,症状通常持续3-6天。
感染后偶尔会发生并发症,包括反应性关节炎(关节疼痛发炎,可持续数月)和格林-巴利综合征。
格林-巴利综合征通常具有脊髓灰质炎样麻痹的症状,可造成呼吸系统以及严重神经系统失常,少数病例或出现死亡。
弯曲杆菌病造成的死亡情况十分罕见,通常局限在年幼或者老年患者,或者那些已经患有基础性疾病的病人,比如艾滋病、糖尿病、癌症等患者。

空肠弯曲菌肠炎,空肠弯曲菌肠炎的症状,空肠弯曲菌肠炎治疗【专业知识】疾病简介空肠弯曲菌肠炎是由空肠弯曲菌引起的急性肠道传染病。
临床以发热、腹痛、血性便、粪便中有较多中性白细胞和红细胞为特征。
弯曲菌最早于1909年自流产的牛、羊体内分离出,称为胎儿弧菌(vibrio fetus),1947年从人体首次分离同该菌疾病病因一、病因(一)传染源主要是动物,弯曲菌属广泛散布在各种动物体内,其中以家禽、野禽和家畜带菌最多。
其次在啮齿类动物也分离出弯曲菌。
(二)传播途径粪一口是主要的传播途径。
(三)易感性人普遍易感。
发展中国家5岁以下的儿童发病率最高,尤其1岁以内者。
发病率随年龄升高而下降。
发达国家卫生条件较好的发展中国家,空肠弯曲菌分离率以10~29岁年龄最高,说明成人对本病的免疫力并不比儿童强。
症状体征一、症状潜伏期1~10天,平均5天。
食物中毒型潜伏期可仅20小时。
初期有头痛、发热、肌肉酸痛等前驱症状,随后出现腹泻、恶心呕吐。
骤起者开始发热、腹痛腹泻。
发热约占56.3~60%,一般为低到中度发热,体温38℃左右。
个别可高热达40℃,伴有全身不适。
儿童高热可伴有惊厥。
腹痛腹泻为最常见症状。
表现为整个腹部或右下腹痉挛性绞痛,剧者似急腹症,但罕见反跳痛。
腹泻占91.9%,一般初为水样稀便,继而呈粘液或脓血粘液便,有的为明显血便。
腹泻次数,多为4~5次,频者可达20余次。
病变累及直肠、乙状结肠者,可有里急后重。
多数1周内自愈。
轻者24小时即愈,不易和病毒性胃肠炎区别;20%的患者病情迁延,间歇腹泻持续2~3周,或愈后复发或呈重型。
婴儿弯曲菌肠炎多不典型,表现为:①全身症状轻微,精神和外表若似无病;②多数无发热和腹痛;③仅有间断性轻度腹泻,间有血便,持续较久;④少数因腹泻而发育停滞。
用药治疗一、西医一、一般治疗消化道隔离,对患者的大便应彻底消毒,隔离期从发病到大便培养转阴。
发热、腹痛、腹泻重者给予对症治疗,并卧床休息。

空肠弯曲杆菌基因
空肠弯曲杆菌是一种革兰氏阴性菌,其基因组包含1,641,481个碱基对和1,654个蛋白质编码基因。
空肠弯曲杆菌基因组的基因密度非常高,94.3%的基因组包含编码基因,使其成为迄今为止被测序的基因密度最高的细菌之一。
空肠弯曲杆菌对盐度、冷冻和低于5的pH值敏感,其生长温度范围也相当窄,最高温度约为46°C,最低温度为30°C。
弯曲杆菌在含氧量低于5%的栖息地生长最好,通常存在于动物的肠道中。
该菌利用其黏附和侵袭能力定植于鸟类和哺乳动物的粘膜表面,并在粘液流中存活。
空肠弯曲杆菌是一种人畜共患病原体,主要通过食物传播给人类。
它可引起人类细菌性腹泻和急性胃肠炎等胃肠道疾病,还可引发败血症、脑炎、心内膜炎及泌尿系统的感染。
严重的感染还会引发神经系统损伤性疾病如格林巴利综合征和米勒综合征。
因此,对空肠弯曲杆菌基因的研究对于了解其致病机制、预防和控制感染具有重要意义。
空肠弯曲菌诊断标准空肠弯曲菌是一种常见的肠道病原菌,可引起人类和动物的腹泻等疾病。
为了准确诊断空肠弯曲菌感染,需要制定相应的诊断标准。
下面将从不同角度详细介绍空肠弯曲菌的诊断标准。
一、临床表现空肠弯曲菌感染的临床表现主要为腹泻、腹痛、恶心、呕吐等症状。
腹泻通常为水样便或黏液便,可伴有血便。
部分患者可能出现发热、乏力等全身症状。
在诊断空肠弯曲菌感染时,应结合患者的临床表现进行综合判断。
二、病原学检查1.细菌培养:从患者的粪便、呕吐物或血液等标本中分离出空肠弯曲菌是确诊感染的关键。
常用的培养基包括选择性培养基和非选择性培养基。
分离出的菌落应进行进一步的鉴定,如形态学观察、生化反应和分子生物学方法等。
2.免疫学方法:利用免疫学方法检测患者标本中的空肠弯曲菌抗原或抗体,如酶联免疫吸附试验(ELISA)、胶体金法等,具有较高的敏感性和特异性。
但需要注意与其他肠道病原菌的交叉反应。
3.分子生物学方法:如聚合酶链式反应(PCR)、基因测序等技术可用于检测空肠弯曲菌的特异性基因片段,具有高度的敏感性和特异性。
这些方法还可用于分析菌株的遗传特征和流行病学调查。
三、血清学检查通过检测患者血清中的空肠弯曲菌特异性抗体,如IgG、IgM等,可辅助诊断感染。
但需要注意抗体的产生需要一定时间,因此血清学检查主要用于回顾性诊断和流行病学调查。
四、影像学检查部分患者可能出现肠道炎症、肠壁增厚等影像学表现,如超声、CT等检查有助于辅助诊断。
但需要注意影像学检查对于早期诊断的敏感性有限。
五、诊断标准制定原则在制定空肠弯曲菌诊断标准时,应遵循以下原则:1.结合临床表现、病原学检查、血清学检查和影像学检查等多方面信息进行综合判断;2.注意与其他肠道病原菌感染的鉴别诊断;3.根据不同地区、人群和流行病学特点制定相应的诊断标准;4.定期更新诊断标准,以适应新的病原学特征和临床需求。
总之,空肠弯曲菌的诊断标准应结合患者的临床表现、病原学检查、血清学检查和影像学检查等多方面信息进行综合判断。